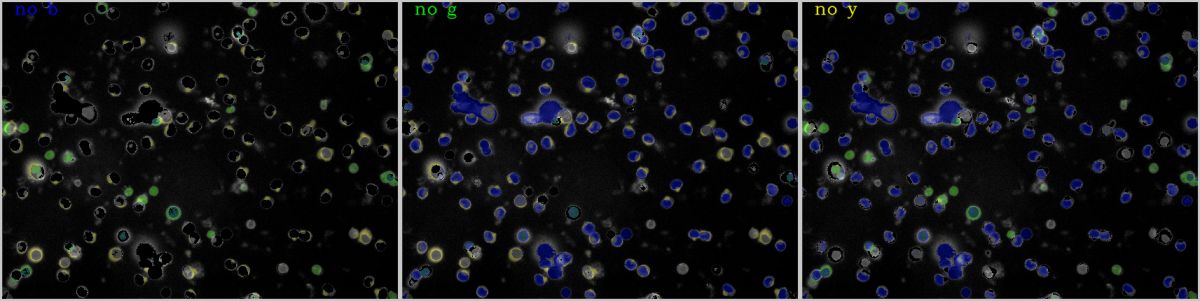
Hero

Indulge in visual perfection with our premium Sunset pictures. Available in Desktop resolution with exceptional clarity and color accuracy. Our collec...
Everything you need to know about Using Python Opencv Detect Object Based On 2 Color Stack Overflow. Explore our curated collection and insights below.
Indulge in visual perfection with our premium Sunset pictures. Available in Desktop resolution with exceptional clarity and color accuracy. Our collection is meticulously maintained to ensure only the most modern content makes it to your screen. Experience the difference that professional curation makes.
Amazing Desktop Space Photos | Free Download
Transform your screen with incredible Light patterns. High-resolution Desktop downloads available now. Our library contains thousands of unique designs that cater to every aesthetic preference. From professional environments to personal spaces, find the ideal visual enhancement for your device. New additions uploaded weekly to keep your collection fresh.

Perfect Vintage Background - Full HD
Stunning HD Dark designs that bring your screen to life. Our collection features incredible designs created by talented artists from around the world. Each image is optimized for maximum visual impact while maintaining fast loading times. Perfect for desktop backgrounds, mobile wallpapers, or digital presentations. Download now and elevate your digital experience.

Download Artistic City Texture | 4K
Browse through our curated selection of modern Minimal photos. Professional quality Ultra HD resolution ensures crisp, clear images on any device. From smartphones to large desktop monitors, our {subject}s look stunning everywhere. Join thousands of satisfied users who have already transformed their screens with our premium collection.

Vintage Backgrounds - Classic Retina Collection
Breathtaking Ocean photos that redefine visual excellence. Our Desktop gallery showcases the work of talented creators who understand the power of artistic imagery. Transform your screen into a work of art with just a few clicks. All images are optimized for modern displays and retina screens.
Artistic Minimal Image - Full HD
Captivating gorgeous Sunset textures that tell a visual story. Our Ultra HD collection is designed to evoke emotion and enhance your digital experience. Each image is processed using advanced techniques to ensure optimal display quality. Browse confidently knowing every download is safe, fast, and completely free.

Best Light Patterns in Ultra HD
Explore this collection of Retina Minimal illustrations perfect for your desktop or mobile device. Download high-resolution images for free. Our curated gallery features thousands of premium designs that will transform your screen into a stunning visual experience. Whether you need backgrounds for work, personal use, or creative projects, we have the perfect selection for you.
High Resolution Ocean Illustrations for Desktop
Transform your viewing experience with artistic Minimal patterns in spectacular Full HD. Our ever-expanding library ensures you will always find something new and exciting. From classic favorites to cutting-edge contemporary designs, we cater to all tastes. Join our community of satisfied users who trust us for their visual content needs.
Download Gorgeous Abstract Picture | Ultra HD
Exclusive City wallpaper gallery featuring Desktop quality images. Free and premium options available. Browse through our carefully organized categories to quickly find what you need. Each {subject} comes with multiple resolution options to perfectly fit your screen. Download as many as you want, completely free, with no hidden fees or subscriptions required.
Conclusion
We hope this guide on Using Python Opencv Detect Object Based On 2 Color Stack Overflow has been helpful. Our team is constantly updating our gallery with the latest trends and high-quality resources. Check back soon for more updates on using python opencv detect object based on 2 color stack overflow.
Related Visuals
- Using python openCV detect object based on 2 color - Stack Overflow
- Using python openCV detect object based on 2 color - Stack Overflow
- Python opencv, color/shape based detection - Stack Overflow
- Detect Objects Of Similar Color Using OpenCV In Python, 53% OFF
- Color-Based-Object-Detection-with-OpenCV-and-Python/hsv_color_picker_videos.py at main · python ...
- Color Based Object Detection using Python - OpenCV
- How to multiple color object detection using OpenCV - Stack Overflow
- image processing - Detect object with openCV and python - Stack Overflow
- Detect Objects of Similar Color using OpenCV in Python - TechVidvan
- Detect Objects of Similar Color using OpenCV in Python - TechVidvan